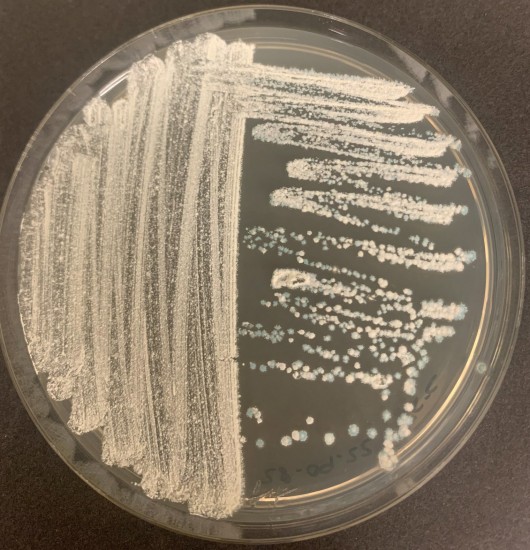

CECT 9355
BACTERIA
Type strain
| Name | Actinoalloteichus fjordicus Nouioui et al. 2025 | ||||
| Strain designation | ADI 127-17 | ||||
| Other collections | DSM 46855 | ||||
| Access in situ (sampling data) | Source: Marine sponge, Antho dichotoma, at 120 m depth in Tautra ridge Country of access: Norway Locality, State of access: Trondheim fjord Date of access: On 22-09-2005 Sampled by: Zotchev, S.B. | ||||
| Isolation data | Isolated by: Zotchev, S.B. Date of isolation: 22-09-2005 Locality, State of isolation: Trondheim | ||||
| History | CECT, 2017 < I. Nouioui, Univ. Newcastle, UK < S.B. Zotchev, Norvegian Univ. of Science and Technol., Trondheim, Norway | ||||
| Growth conditions | Culture media: 30 Growth temperature (in °C): 26 Incubation time: 7d Atmospheric needs: aerobic Cultivation conditions for CECT strains | ||||
| Restrictions | Risk group: 1 CECT MTA | ||||
| Genetic data | G+C mol%: 70.09 mol% 16S rRNA sequence: MF440323 Complete genome sequence: CP016076 | ||||
| Delivery |
| ||||
| La CECT sigue estándares de calidad para garantizar la viabilidad, pureza y autenticidad de las cepas que conserva. La información mostrada en esta ficha procede de diversas fuentes. Algunas de las propiedades no han sido necesariamente contrastadas por la CECT | |||||